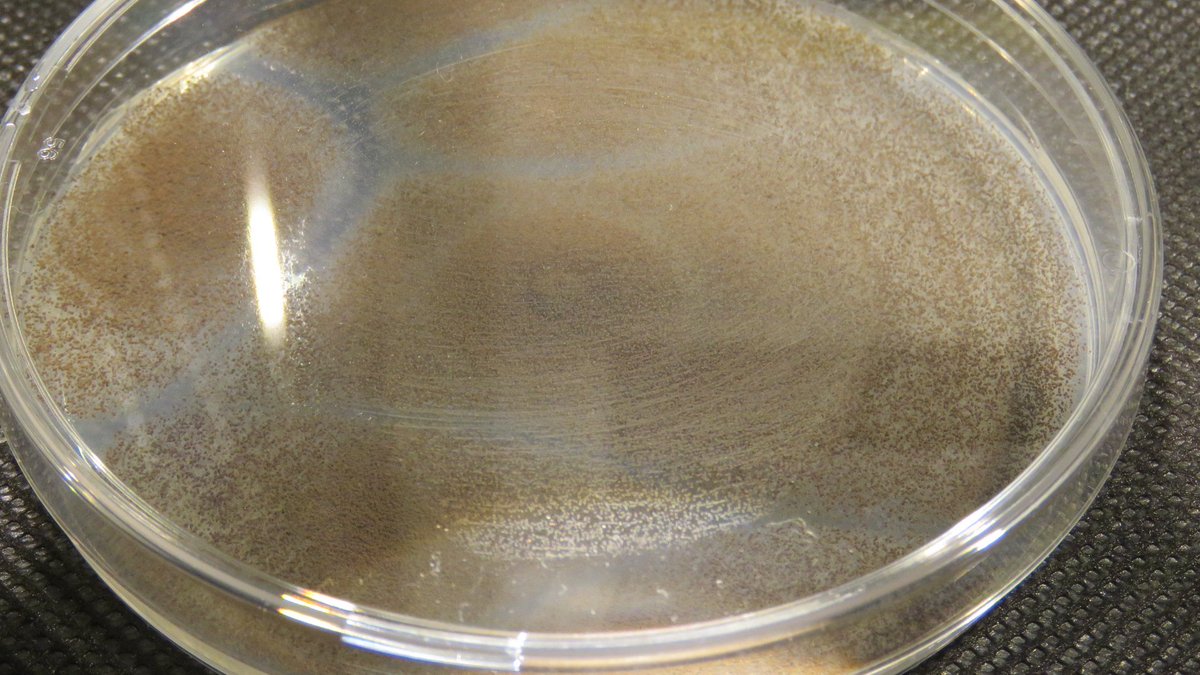

【新色追加】日本製 職人手塗り仕上げ ティッシュケース ペーパーポット おしゃれ トイレットペーパー ティッシュカバー かわいい 丸型 アイコレクション 日本製 韓国 丸 北欧 引越し 新築祝い 母の日
2,970円
11687 customer ratings
4.72 ★★★★★
商品名 ペーパーPot(ペーパーポット) 商品説明 コロンとした球体型の壷からティッシュペーパー・ロールペーパーが出てくる驚きと楽しさ。 デザイン性の高さが評価され、GOOD DESIGN2008を受賞しました。販売開始以来、今もなお愛され続けているロングセラー商品です。…

![[1,500円OFFクーポン/有名ショップ]\12%OFF/冷蔵庫 冷凍庫 小型 2ドア 130L 家庭用 PRR-142D 1人暮らし レトロ冷凍冷蔵庫 おしゃれ かわいい レトロ キッチン家電 生活家電 新生活 一人暮らし ひとり暮らし パステルカラー ブラック オフホワイト ライトグリーン[SS]](https://thumbnail.image.rakuten.co.jp/@0_mall/irisplaza-r/cabinet/11073544/11750856/7160369-7160371.jpg?_ex=145x145)





